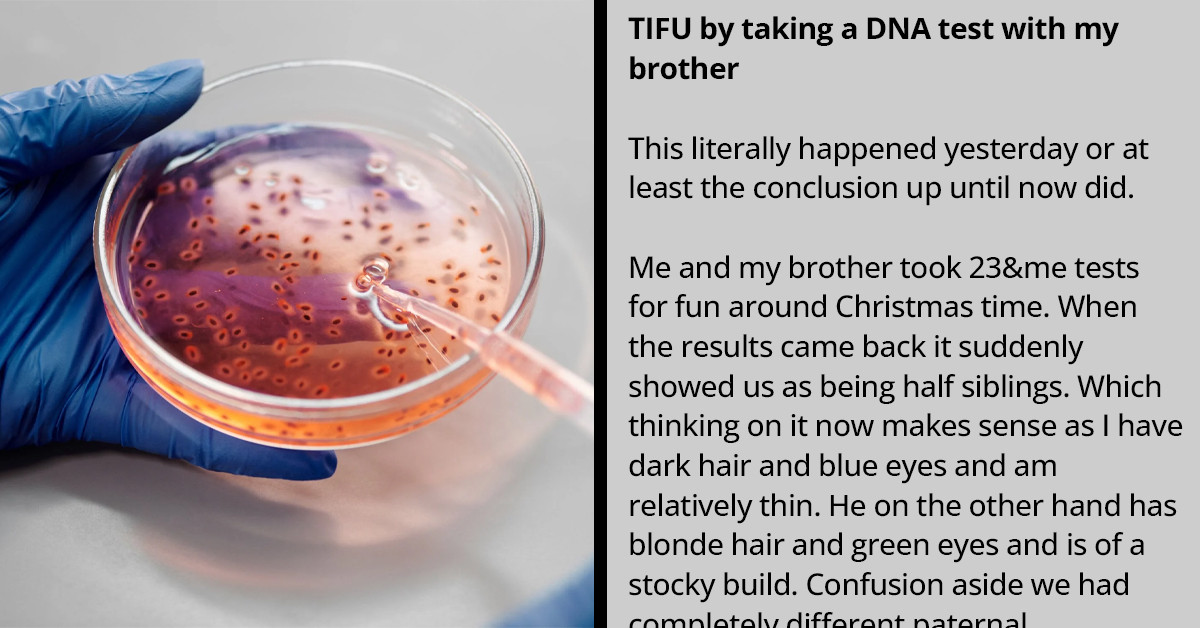
Man Shares How He Discovered That His Daddy Is Not His Father and People Online Offered Their Suggestions

Man Shares How He Discovered That His Daddy Is Not His Father and People Online Offered Their Suggestions
If you go looking for something, you’ll surely find it, literally.
The world is a beautiful place, but it can also be a mystery waiting to be solved. When you’ve built your whole world around your family, there’s nothing that could go wrong, but all of a sudden, DNA comes knocking.
So many marriages have been broken due to a simple DNA test. So many relationships have been tarnished because of a DNA test.
This makes one realize that if you go looking for something, you’ll surely find it, literally. A Redditor named u/jakobpinders has taken to the TIFU subreddit page to share his story, and as you can already tell, it’s all about the results of a DNA test.
According to the story, the OP and his brother took a DNA test for fun, but it was discovered that they were half-siblings. The OP confronted his mom, and it was revealed that his father "was a drifter and an alcoholic who was raised in the foster system and who never knew his real family."
The mother added that his father never wanted him and was a "deeply lost person but also an extremely intelligent individual; however, the foster system left him broken." The thing is, the OP’s father is already dead, and the only thing he has is a... Pause!
Read the full story in the OP’s own words below.
Took a DNA test with my brother...
 u/jakobpinders
u/jakobpindersTaking DNA tests for fun around Christmas time
 u/jakobpinders
u/jakobpindersI confronted my mum
 u/jakobpinders
u/jakobpinders
My real father was an alcoholic
 u/jakobpinders
u/jakobpinders
He died years ago from liver damage
 u/jakobpinders
u/jakobpinders
I know who my real father is
 u/jakobpinders
u/jakobpinders
To wrap everything up...
 u/jakobpinders
u/jakobpinders
The post received over 850 comments and more than 14K upvotes. Below are what people had to say!
1. Felt like my world was shape-shifted
 u/Dry-Detective3852
u/Dry-Detective3852
2. Identifying the body of someone you didn't know
 u/Beautiful-Concern144
u/Beautiful-Concern144
3. Though he's not your biological dad, he's your real father
 u/princess_nyaaa
u/princess_nyaaa
4. Go give your dad a real hug
 u/bmsh948549
u/bmsh948549
5. Some people don't deserve the title DAD
 u/shainadawn
u/shainadawn
6. He might have been your father, but not your daddy
 u/commandrix
u/commandrix
7. You need to put together all that you know
 u/Ecfective_Corner694
u/Ecfective_Corner694
8. Very true...
 u/igraywolf
u/igraywolf
9. You could have loads of siblings you don't even know
 u/AllanfromWales1
u/AllanfromWales1
10. There are people who work tirelessly to reconnect individuals with their genetic families
 u/Minijcwdriver
u/Minijcwdriver
11. This is great
 u/ComfortableWish
u/ComfortableWish
12. It feels like that decision was stolen from me...
 u/virgilreality
u/virgilreality
13. He's not your real dad...
 u/demon_ix
u/demon_ix
14. It cannot be changed, and it changes nothing
 u/PiddlyD
u/PiddlyD
15. Your father is the one who raised you
 u/cofclabman
u/cofclabman
16. This is another angle to consider
 u/kiasyd_childe
u/kiasyd_childe
17. That you did the deed doesn't make you the father
 u/luther2399
u/luther2399
18. And I so agree with you
 u/lablaga
u/lablaga
19. He's your father, maybe, but he's not your daddy
 u/TeysaMortify
u/TeysaMortify
20. Learn more for yourself somehow
 u/achilles5788
u/achilles5788
21. I couldn't have said it any better
 u/ukexpat
u/ukexpat
22. Always was your father and always will be
 u/another_nosbiht
u/another_nosbiht
23. Do not sweat it at all
 u/Nic4379
u/Nic4379
24. A relevant way to see things
 u/twohedwlf
u/twohedwlf
25. And it is as clear as day
 u/id_death
u/id_death
So many people have been left broken due to the results of a DNA test. You can imagine waking up only to find out that the family you’ve known all your life is not your biological family.
Damn! It can be a hard pill to swallow because, from that moment, you start pinpointing things that make you different from them. But then, it is what it is!




